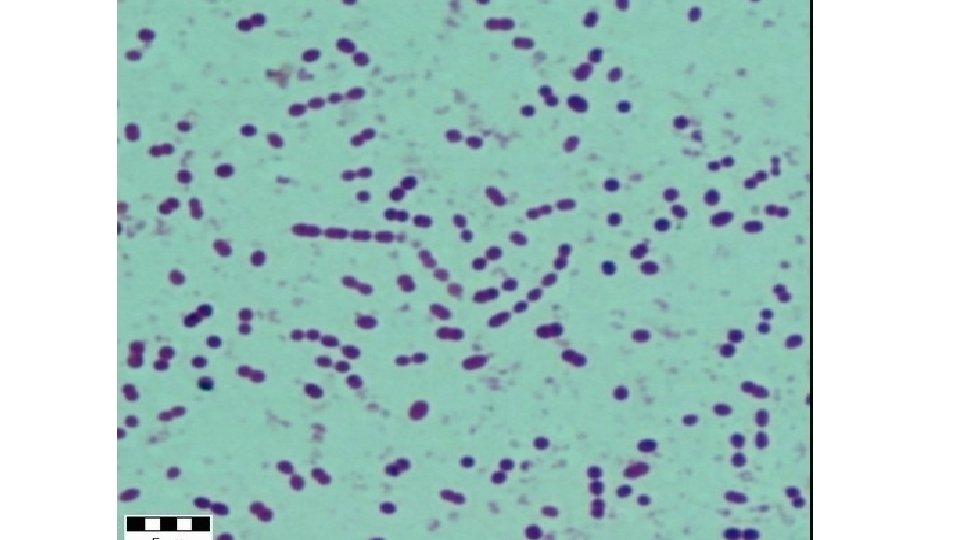

Meningitis Lec 2 SUMMARY of Last lecture Headache

- Slides: 40
Meningitis Lec. 2
SUMMARY of Last lecture Headache NECK STIFFNESS KERNIG sign Fever Brudziński's sign Photophobia? Vomiting MENINGITIS
SUMMARY Headache NECK STIFFNESS Fever Photophobia? Vomiting Consciousness Seizures 2 Focal signs KERNIG sign Brudziński's sign Encephalitis
Ventriculitis
Cortical Infarcts
Inflammation around vessels
Subpial Encephalopathy
Inflammation of Cranials
https: //www. youtube. com/watch? v=o__Ymsma 4 q. E
https: //www. youtube. com/watch? v=YXi. RWVP-l. Ak
Cases • A 23 year old patient was admitted to a general hospital for the complaint of headache, low grade fever and lassitude which gradually evolved over 3 weeks, had mild neck stiffness and had papilledema. CXR was CLEAR and Tuberculin test was negative. Was treated empirically for bacterial meningitis for two weeks, all symptoms improved and optic fundi became normal. The patient was discharged well. 10 days after discharge the patient DIED! How to explain the cause of death?
Fig. 1. Pathogenesis of TBM and postulation of the formation of Rich foci. (a) Aerosol transmission of MTB, ( images/alveoli-268. htm) (b) Phagocytosis of MTB by alveolar macrophages inside alveoli. (c) Granuloma formation in the lung, which subsequently occurs due to cellular and cytokine network responses; 90% of hosts with granulomas maintain them stably over the course of their lives. (d) MTB escapes from the granuloma, which occurs in 10% of latent TB patients. (e) MTB can cause TBM by escalating from the lung or by secondary reactivation from a “leaked granuloma”, which is then filtered into a regional lymph node. ( images/alveoli-268. htm) (f) After spreading through the blood circulation, MTB can enter the CNS through the BBB, likely by a Trojan horse mechanism. (g) Bacilli seed to the meninges or the brain parenchyma, forming subpial or subependymal primary complexes,
Case II • A 24 year old patient presented to the emergency unit complaining from headache, low grade fever and vomiting for 3 weeks, on examination mild neck stiffness was found. CSF exam showed protein 240 mg/dl, normal sugar and 200 cells: 40% Neutrophils and 60% Lymphocytes. • MRI showed:
• What is the most likely diagnosis? • The patient was treated, discharged home on steroids and anti-TB medications. • Three weeks later: Sever Headache, Vomiting, Weakness and Blurring of vision. • ?
• What is the management?
LUMBAR PUNCTURE • Upon doing lumbar puncture to a patient with meningitis, Manometry reveled opening pressure of 350 mm H 2 O, the doctor continued tapping and the patient suddenly collapsed uncousciouse, with bradycardia, high pulse pressure, flaccid quadri-paresis and difficulty in breathing? The patient DIED few minutes later? • What happened? • What should have been done to prevent that?
Other CSF parameters • Manometry • Gram stain • Sereological • Procalcitonin • PCR
Differential Diagnosis • Meningitis: -Subarachoid Hemorrhage -Venous Sinus Thrombosis - Encephalitis • Encephalitis - Venous Infarction - Hemorrhagive Leucoencphalitis - Meningitis
Investigations • CBC & ESR, U&E, LFT, Nasopharyngeal swab, Blood cultures • LP • CXR • CT scan & MRI brain , also for sinuses, otitis media, and other parameningeal source. • EEG • MRV & MRI • Tuberculin test • HIV screen
Steroids • Pyogenic Meningitis: Dexamethason: 4 mg q 6 h iv x 4 d • Herpes Simplex encephalitis: Dexamethason 8 mg q 12 h x 4 d • TB: 8 mg iv q 12 h x 20 days
Antimicrobial therapy
Antimicrobial therapy • Specific
Prophylaxis Of meningococcal M. • Households, close contact (children) • Rifampicine: po q 12 h x 2 d • <1 year -> 5 mg/kg/dose • >1 year -> 10 mg/kg/dose • Adult: 600 mg/dose OR • Single dose Ciprofloxacin 500 mg
Complications • Hydrocephalus • Cranial nn palsies • Stroke • Dementia • Amnesia • Aphasias • Venous sinus thrombosis • Death
CNS infections • Meningitis • Encephalitis • Parameningeal: venous sinuses, mastoiditis, sinusitis, otitis media, brain abcess • High suspecision for TB • Clinically: headache, fever, vomiting +/- altered mental status, seizures, focal neurological signs • Boold culture, empirical antimicrobials + anti-inflammatory (steroids) • LP if no evidence of significant mass lesion • Specific treatment for 2 -3 weeks and 9 m to 1. 5 year for TB